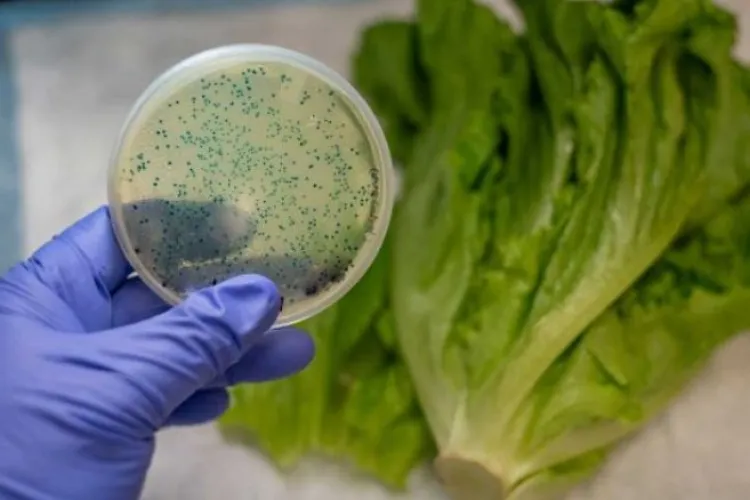
Norovirusul face ravagii în România. Val de internări din cauza transmiterii rapide

Mircea Lucescu, internat de urgență după un episod medical grav! Ce au descoperit medicii la spital: „Se află sub îngrijirea echipelor medicale”
Mircea Lucescu a fost internat de urgență după ce i s-a făcut rău în cantonamentul naționalei României. Medicii au confirmat o tulburare majoră de ritm cardiac, iar selecționerul rămâne sub supraveghere medicală la Spitalul Universitar din București
A murit Chuck Norris! Legenda filmelor de acțiune s-a stins din viață la vârsta de 86 de ani
A murit Chuck Norris! Legenda filmelor de acțiune s-a stins din viață la vârsta de 86 de ani
Cel mai bătrân clujean, veteran de război, avansat general chiar de ziua lui: Împlinește 110 ani!
Iosif Rus, colonel în retragere și unul dintre cei mai vârstnici veterani de război din România, va fi avansat la gradul de general de brigadă la aniversarea de 110 ani, într-o ceremonie emoționantă organizată la Gherla, în semn de recunoaștere a curajulu
Al doilea accident în doar două ore pe drumul Cluj-Napoca - Gherla! Trei mașini au fost implicate. Trafic complet blocat
Un accident rutier a fost semnalat în jurul orei 18.45, între localitățile Livada și Gherla pe DN1C, care leagă Cluj-Napoca de Gherla
A murit Mihai Leu. Ce boală cruntă l-a răpus pe marele campion boxer la doar 56 de ani
Mihai Leu, una dintre cele mai emblematice figuri din sportul românesc, a murit marți seară, la vârsta de 56 de ani, după o lungă confruntare cu cancerul. Vestea tristă a fost confirmată printr-un mesaj publicat pe pagina sa oficială de Facebook.
Cursă contra cronometru: Un copil de 11 ani, transferat de urgență la Cluj pentru o intervenție neurochirurgicală vitală
Un băiat de doar 11 ani a fost transferat de urgență de la Chișinău la Cluj-Napoca, pentru a primi tratament neurochirurgical specializat. Micuțul avea nevoie de o intervenție de înaltă performanță, care nu putea fi realizată în Republica Moldova
Șepcile Roșii, mesaj emoționant și apel pentru Robi: „Omul ăsta de o frumusețe imposibil de cuprins are nevoie de noi”
Șepcile Roșii au transmis un mesaj emoționant pentru Robi: „Omul ăsta de o frumusețe imposibil de cuprins are nevoie de noi”
Teroare într-un cazino din Cluj! Mai mulți clienți s-au baricadat înăuntru, după atacul unui dependent de păcănele
Un incident grav a avut loc în sala de jocuri de noroc „Bellagio” situată în cartierul Mănăștur din Cluj-Napoca.
Cățelul Pedro, salvat dintr-o benzinărie din Cluj, umblă din nou! Iubitorii de animale s-au mobilizat exemplar - VIDEO
Cățelul Pedro, preluat în 20 octombrie dintr-o benzinărie din Turda, după ce nu își putea folosi picioarele din spate, a fost salvat și acum umblă binișor. Efortul medicilor, donatorilor și voluntarilor a fost unul foarte mare.
Acuzații de mușamalizare a unui accident, în care a fost implicat omul de afaceri controversat, Adrian Marțian: A mutat mașina și poliția m-a intimidat!
Un motociclist a fost victima unui accident petrecut în 18 septembrie pe strada Fagului, care leagă cartierul Bună Ziua de cartierul Gheorgheni, și face legătura cu strada Constantin Brâncuși.
S-a stins din viață Silvio Berlusconi! Fostul premier al Italiei se confrunta cu o boală gravă la 86 de ani
Vești șocante venite din Italia. S-a anunțat moartea fostului premier italian, Silvio Berlusconi. Medicii spitalulului San Raffaele din Milano au făcut anunțul.
Ministerul Sănătății, precizări despre cazul de hepatită misterioasă care face ravagii în rândul copiilor
Ministerul Sănătăţii informează că în România a fost raportat un caz de hepatită acută severă la un copil. Reacția vine după ce au apărut informații în spațiul public, potrivit cărora o formă de hepatită rară, de origine necunoscută a apărut și la noi în
Norovirusul face ravagii în România. Val de internări din cauza transmiterii rapide
Norovirusul face ravagii în România. Val de internări din cauza transmiterii rapide. Dr. Adrian Marinescu: „Trebuie să ne protejăm!”
Cocktail-ul anti-COVID cu care a fost tratat Donald Trump a fost introdus în spitalele din Germania. O doză costă 2.000 de euro
Germania este prima țară din Uniunea Europeană care introduce cocktail-ul folosit de Donald Trump în tratamentul anti-COVID-19.
Numărul deceselor cauzate de coronavirus a ajuns la aproape 1.700. O persoană a murit și în Europa
Numărul deceselor cauzate de coronavirus a ajuns la aproape 1.700. O persoană a murit și în Europa
Donald Trump cere pedeapsa cu moartea pentru teroristul de la New York
Președintele Statelor Unite ale Americii cere pedeapsa capitală pentru teroristul responsabil de atentatul de la New York, soldat cu moartea a 8 persoane.
Concertul DEPECHE MODE de la Cluj va avea loc. DAVE GAHAN a fost spitalizat. Care este starea lui acum
Trupa britanică Depeche Mode și-a anulat concertul din Belarus, după ce Dave Gaham a fost spitalizat.
Florian Walter se află în SPITAL, în stare gravă. Stresul și necazurile l-au doborât și în Dubai
Patronul U Cluj a ajuns în spital și este în stare gravă.
Toni Doboş a recunoscut că a luat MITĂ de la Becali în DOSARUL VALIZA
Fostul președinte al U Cluj, Toni Doboş, și-a recunoscut vina în Dosarul Valiza și a semnat un acord cu procurorii DNA. El a admis că a primit 1,7 milioane de euro de la Becali ca să nu piardă cu CFR Cluj.
Un pacient a câştigat în instanţă banii pe care i-a cheltuit pe medicamente în spital
Un bărbat a dat în judecată spitalul în care a fost internat și a cerut decontarea medicamentelor pe care le-a plătit din propriul buzunar în perioada în care a fost spitalizat, iar unitatea medicală nu avea respectivele medicamente.
Teorie ŞOCANTĂ!Eminescu a fost asasinat
Despre moartea lui Mihai Eminescu au existat de-a lungul timpului mai multe teorii, dar nici una dintre ele nu a putut fi demonstrată cu probe concrete. Un scriitor încearcă să facă lumină în acest caz.
Facebook a ajutat la diagnosticarea unei boli neidentificata nici macar de medici
Platforma de socializare Facebook a ajutat la diagnosticarea unei boli careia nici macar medicii nu au reusit sa-i dea de capat.
Mubarak este in coma si chiar pe moarte, scrie presa internationala!
Fostul presedinte al Egiptului, Hosni Mubarak, este in coma de sambata, dupa ce si-a pierdut cunostinta la resedinta lui de la Sharm-al-Sheik.
Dinu Patriciu a fost internat in spital in ziua in care a implinit 60 de ani
Omul de afaceri Dinu Patriciu a suferit o hemoragie digestiva, a acuzat dureri abdominale si a vomitat sange, chiar in timpul petrecerii de la Venetia.